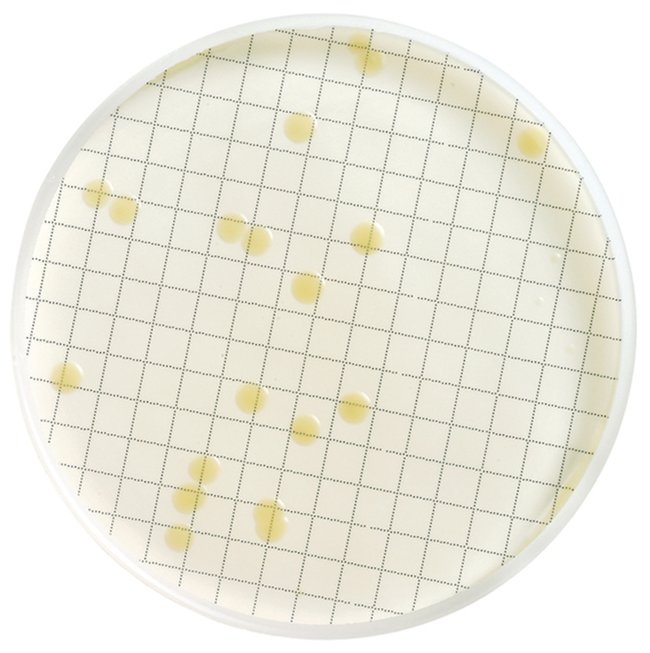

Nutrient Media, Pack Of 50
$ 221.63
|
|
Details:
Developed specifically for culturing microorganisms on membrane filters; select media type to match organism type and analytical test need
Additional Information
| SKU | 10143264 |
|---|---|
| UOM | 1 Pc |
| UNSPSC | 41106200 |
| Manufacturer Part Number | MHA000P2T |
